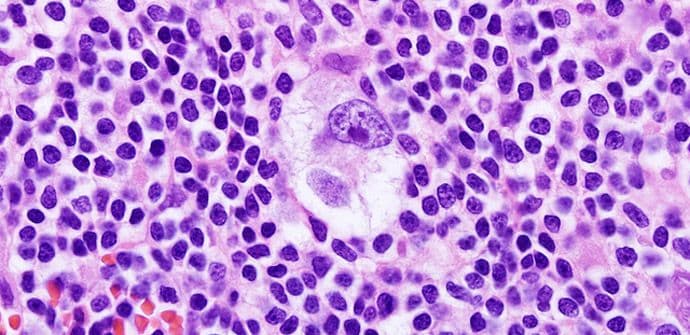
Novi lijek za Hodžkinov limfom pokazao odlične rezultate Novi lijek za Hodžkinov limfom pokazao odlične rezultate

Hodžkinov limfom je oblik kancera bijelih krvnih zrnaca i jedan od najčešćih oblika raka mladih osoba i djece. Naučnici kažu da iako sada dostupni tretmani uspijevaju da drže bolest pod kontrolom, kod čak četvrtine pacijenata bolest se u jednom trenutku vraća.
Direktor Programa za imunoterapiju limfoma Icahn Medicinskog fakulteta u Mont Sinaju (Njujork) Džošua Brodi ističe da kod onih pacijenata koji ne reaguju na hemoterapiju, Hodžkinov limfom obično dovodi do fatalnog ishoda.
Međutim, nedavna studija uključila je 23 pacijenta sa neizlječivim Hodžkinovim limfomom, od kojih je trećina isprobala barem šest različitih oblika liječenja, ali bez uspjeha. Četiri petine koristilo je i terapiju matičnim ćelijama, ali ni to nije pomoglo.
Prva faza istraživanja uključila je novi lijek - nivolumab, oblik liječenja koji “tjera” imuni sistem da se bori protiv ćelija raka.
Naučnici kažu da je nakon terapije, kod četiri pacijenta nije bilo primjetnog karcinoma, dok je kod 16 smanjen za polovinu. Poslije šest mjeseci, 86 odsto njih bilo je živo i nastavljalo da opaža pozitivne efekte liječenja.
Naučnici kažu da je američka Agencija za hranu i ljekove označila nivolumab kao revolucionarnu terapiju za oboljele od ove bolesti, pa je već u planu druga faza istraživanja koja bi trebalo da obuhvati veći broj ispitanika.
Foto: Qiao's Pathology (Art and Science in Medicine) / Flickr.com; capitalotc.com